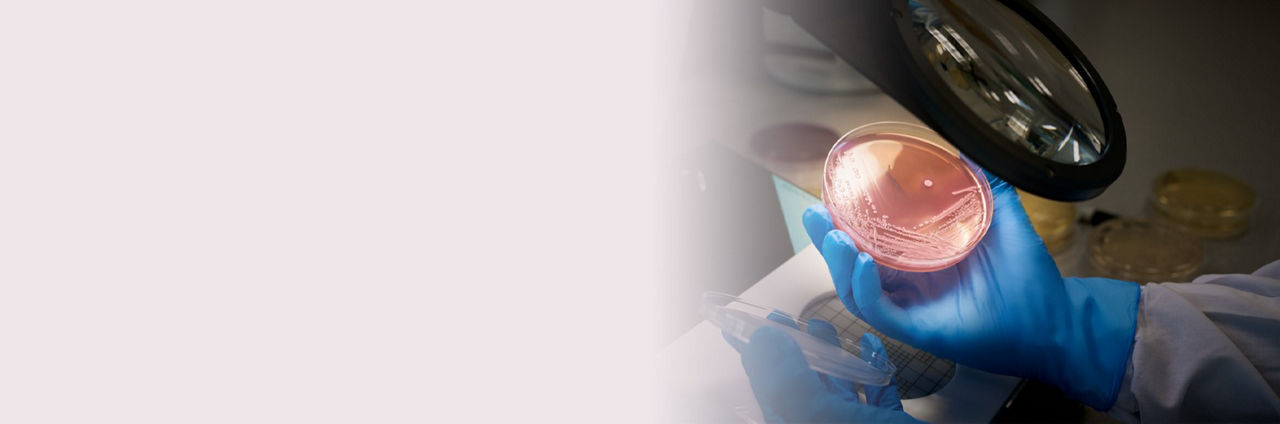
NOUTĂȚI MEDICALE ALTE ARII TERAPEUTICE_1

Roche lansează Institutul de Biologie Umană pentru a accelera progresele în cercetare și dezvoltare prin deblocarea potențialului sistemelor bazate pe modele biologice umane
Roche lansează Institutul de Biologie Umană pentru a accelera progresele în cercetare și dezvoltare prin deblocarea potențialului sistemelor bazate pe modele biologice umane
- Institutul de Biologie Umană își propune să prezică mai bine care candidați la medicamente sunt siguri și mai eficienți la pacienți, prin evoluția și creșterea utilizării sistemelor bazate pe modele biologice umane.
- Sistemele bazate pe modele biologice umane sunt „replici” vii în miniatură ale țesuturilor și organelor umane care au, de asemenea, potențialul de a reduce dependența de testarea pe animale.
- Institutul reunește oameni de știință din mediul academic și din industrie pentru a conduce adoptarea pe scară largă a sistemelor model umane în cercetarea și dezvoltarea farmaceutică, precum și în practica clinică.
4 May 2023 - Roche a anunțat lansarea Institutului de Biologie Umană (IHB), care se concentrează pe avansarea cercetării în domeniul sistemelor bazate pe modele biologice umane, cum ar fi organoidele. Folosind aceste sisteme, institutul își propune să accelereze descoperirea și dezvoltarea medicamentelor prin îmbunătățirea înțelegerii modului în care funcționează organele și a modului în care se dezvoltă bolile. În cele din urmă, acest lucru va ajuta la aducerea medicamentelor la pacienți mai rapid. Aceste eforturi vor permite, de asemenea, testarea timpurie a candidaților de medicament care sunt siguri și care molecule ar funcționa cel mai bine pentru fiecare pacient.
Sistemele bazate pe modele biologice umane sunt „replici” vii în miniatură 2D sau 3D ale țesuturilor și organelor umane pe care oamenii de știință le creează din celule stem umane. Oglindind biologia umană și a bolii cu mai multă acuratețe decât modelele animale, ele pot ajuta, de asemenea, la reducerea dependenței de testarea pe animale. În plus, aceste sisteme pot permite descoperirea de noi biologii umane (în sănătate și boală) și identificarea țintelor de medicamente care sunt imposibil de găsit cu abordările clasice de descoperire.
Mai multe detalii despre această ştire aici.
